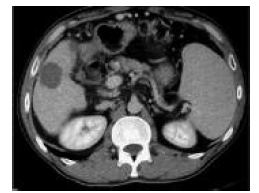

Volume: 12 Issue: 1 March 2014 - Supplement - 1
FULL TEXT
Surgical options for hepatocellular carcinoma must be considered first; if not, image-guided tumor ablation is recommended. The Barcelona Clinic Liver Cancer classification system is commonly used for patients with hepatocellular carcinoma. This classification system is important for image-guided tumor ablation. According to Barcelona Clinic Liver Cancer system, percutaneous tumor ablation is recommended for early stage hepatocellular carcinoma.
Hepatocellular carcinoma nodules smaller than 2 cm, not subcapsular or perivascular, are ideal nodules for image-guided radiofrequency ablation. In patients with early hepatocellular carcinoma, the rate of complete response is approximately 97%, with a 68% of 5-year survival rate. Early stage hepatocellular carcinoma includes patients with preserved liver function (Child-Pugh score A or B), with solitary hepatocellular carcinoma, or up to 3 nodules less than 3 cm. it is important to the success of radiofrequency ablation to ablate all viable tumor cells and to create tumor-free margin. The best results are achieved if the tumor is less than 3 cm. If the tumor is between 3 and 5 cm, the success rate of radiofrequency ablation is decreased. Therefore, combination treatment has emerged for better results if the hepatocellular carcinoma nodule is larger than 3 cm and smaller than 5 cm.
Radiofrequency ablation offers better survival than ethanol injection if the nodule larger than 2 cm. Microwave ablation can cause higher intratumoral temperatures, larger tumor ablation volumes, and faster ablation times. However, no statistically significant differences were observed between the two.
A nonchemical and nonthermal image-guided ablation technique is irreversible electroporation. Irreversible electroporation causes irreversible disruption of the cell membrane integrity by changing the transmembrane potential. One advantage of this technique is complete ablation of the margin of the vessels. It can be applied to the nodules that is centrally located.
Key words : Hepatocellular carcinoma, Ablation
Introduction
Hepatocellular carcinoma is the fifth most common cancer in the world and the third leading cause of cancer-related death.1 The number of cases diagnosed with hepatocellular carcinoma is expected to increase in Western countries.2 A careful multidisciplinary assessment of tumor characteristics, liver function, and physical status is required for proper therapeutic management. Therapeutic approaches for treating hepatocellular carcinoma can be classified into 3 categories: (1) potentially curative, (2) palliative, and (3) symptomatic. Potentially curative treatments including liver resection and transplant are associated with promising 5-year survival rates of up to 75%. However, because of a shortage of donor livers, advanced tumor stage, or liver dysfunction, less than 20% hepatocellular carcinoma patients are eligible for such treatments.3,4 If surgery is precluded, local nonsurgical therapies are applied. Percutaneous treatments provide good results (5-year survival of 40%-50%), but our unable to achieve response rates and outcomes comparable to those for surgical treatments.5
The Barcelona Clinic Liver Cancer staging classification links the stage of the disease to a specific treatment strategy.6,7 Percutaneous treatments are currently considered minimally invasive procedures. According to the Barcelona Clinic Liver Cancer staging system, image-guided tumor ablation is recommended in patients with early stage hepatocellular carcinoma. Tumor ablation is achieved by modifying the temperature of neoplastic cells (radiofrequency, microwave, laser, and cryoablation) or by using chemical substances (alcohol, acetic acid).8
Radiofrequency ablation for hepatocellular carcinoma
The alternating current passing down electrode tip into surrounding tissue
generates changes in the direction of ions and creates ionic agitation and
frictional heat. The radiofrequency ablation effect depends on duration,
temperature, organ perfusion, tissue density, and electrolyte concentration.
Above 60°C, instant protein denaturation, melting lipid bilayer, destruction of
RNA, DNA, and enzymes occur during radiofrequency ablation.9 There are different
types of radiofrequency ablation needles: retractable needle electrodes and
insulated hollow needle electrodes. Radiofrequency ablation can be applied to
patient using image guidance (Figures 1-4). Most frequently, ultrasound and
computerized tomography used to place the needle. Magnetic resonance imaging
also can be used. Sometimes, a combination of these methods are necessary. The
procedure is performed under anesthesiologic assistance by conscious sedation
using midazolam and fentanyl. If necessary, propofol is added.
Microwave for hepatocellular carcinoma
Microwave ablation uses dielectric hysteresis to produce heat. Tissue
destruction occurs, when tissues are heated to lethal temperatures from an
applied electromagnetic field, typically at 900-2.500 MHz. Unlike
radiofrequency, microwave ablation can readily penetrate through the charred or
desiccated tissue.10 There are advantages to microwave ablation over
radiofrequency ablation. Faster ablation times, larger ablation zones, and
higher intratumoral temperatures have been observed.11
Percutaneous ethanol injection for hepatocellular carcinoma
Percutaneous ethanol injection causes cytoplasmic dehydration, protein
denaturation, and small vessel thrombosis, result in coagulative necrosis. The
advantages of percutaneous ethanol injection are its low cost, its application
ease, and it may be applied as an additive to other ablative procedures.
Disadvantages include a difficulty of diffusion through fibrous septa, multiple
repeated injections, and higher recurrence rate.12 Five randomized controlled
trials have compared radiofrequency ablation versus percutaneous ethanol
injection for treating early stage hepatocellular carcinoma. These studies
showed that radiofrequency ablation has a higher anticancer effect than
percutaneous ethanol injection, leading to a better control of the disease
(2-year local recurrence rate: 2%-18% vs 11%-45%).13 Radiofrequency ablation
significantly improved survival, and reduces local recurrence compared with
percutaneous ethanol injection. Percutaneous ethanol injection should be
reserved for cases in which radiofrequency ablation is not technically possible
(pericholecystic lesions or lesions near the hepatic hilum).6,7
Irreversible electroporation
Irreversible electroporation is a technique that can be used for hepatocellular
carcinoma lesions. High voltage pulses are applied to tissues to permeabilize
the cell membranes irreversibly. Irreversible electroporation uses nonthermal
based method of action and does not destroy tissue architecture, which is why
the biliary system and intestinal vessels intestine remain intact. Irreversible
electroporation has no charring effect or heat sink effect as seen in
radiofrequency ablation.14
Very early stage hepatocellular carcinoma is defined as a solitary hepatocellular carcinoma with a diameter of < 2 cm. Patients with small solitary nodule with Child-Pugh class A disease and an absence of microvascular invasion and dissemination are good candidates for surgical resection. After resection, such patients have a 5-year survival rate of better than 75%.15 Nodules smaller than 2 cm that are not subcapsular or perivascular are the ideal target for percutaneous radiofrequency ablation.16 The response rate after ablation is about 97%, with a 5-year survival rate of 68%.17 If the location of the tumor is not optimal for radiofrequency ablation, then percutaneous ethanol injection can be performed as an ablative therapy.18
Early stage hepatocellular carcinoma includes patients with preserved liver function with solitary hepatocellular carcinoma or up to 3 nodules less than 3 cm in size. Approximately 25% of all hepatocellular carcinoma patients are diagnosed with early stage hepatocellular carcinoma. Liver resection or liver transplant should be considered when patients present with a solitary tumor and no portal hypertension. Local ablation is considered when patients are excluded from surgical options.19 Radiofrequency ablation is considered to be the best ablative therapy in patients with early stage hepatocellular carcinoma. In patients with Child-Pugh class A disease and early stage hepatocellular carcinoma, 5-year survival rates are as high as 51% to 64%.20
Radiofrequency ablation technique has been proven itself to be a safe and effective treatment for small hepatocellular carcinoma. However, it is difficult for radiofrequency ablation to achieve complete ablation when treating relatively large hepatocellular carcinoma.21 Hepatocellular carcinoma nodule size can effect survival outcomes after ablation. Larger tumors are more likely to be associated with micrometastatic spread to local or distant tissues. Several recent systematic reviews has shown that a 3-cm breakpoint to differentiate local recurrence and survival outcomes after ablation.22,23 Lu and associates proved that if the hepatocellular carcinoma nodule was more than 3 cm, it is possible that 50% of hepatocellular carcinoma volume can be completely ablated.24 Also, a study carried by Brillet and associates demonstrated that even after complete ablation of a hepatocellular carcinoma nodule, there was possibility of 44% live satellite nodules around the ablated zone for hepatocellular carcinoma.25 Therefore, in recent years, the combination of interventional therapies has been widely performed when treating hepatocellular carcinoma.
One such combined strategy is the combination of radiofrequency ablation and transarterial chemoembolization. A combination of transarterial chemoembolization followed by radiofrequency ablation has been used to minimize heat loss because of perfusion-mediated tissue cooling and to increase the therapeutic effect of radiofrequency ablation (Figures 5-9).26 Radiofrequency ablation and transarterial chemoembolization are more effective for complete tumor necrosis rate in patients with hepatocellular carcinoma.21,27 Local tumor progression rate was significantly lower in the transarterial chemoembolization and radiofrequency ablation-treated group than in the radiofrequency only ablation group (6%-39%).28
To evaluate the ablated hepatocellular carcinoma nodule regarding residual tissue or recurrence and possible complications, a quadriphasic spiral computed tomography or magnetic resonance imaging was performed 6 to 10 weeks after treatment. A hypodense ablated zone without enhancement or thin linear enhancement, or a decrease in size during follow-up, shows complete ablation (Figure 10). Thick nodular, irregular enhancement around ablated area and increase in size during follow-up shows local recurrences (Figure 11).
The hepatocellular carcinoma surveillance program is important in making an early diagnosis and in planning curative therapy. Image-guided percutaneous ablation is the first choice for patients with early stage hepatocellular carcinoma if the patient is not suitable for surgical resection or liver transplant. Combined treatment modalities can be applied to hepatocellular carcinoma nodules, if the lesion size between 3 to 5 cm in diameter, to increase the effectiveness of both procedures.
References:
- McGlynn KA, London WT. Epidemiology and natural history of
hepatocellular carcinoma. Best Pract Res Clin Gastroenterol.
2005;19(1):3-23.
CrossRef - PubMed - Venook AP, Papandreou C, Furuse J, de Guevara LL. The incidence and
epidemiology of hepatocellular carcinoma: a global and regional perspective.
Oncologist. 2010;15(suppl 4):5-13. doi: 10.1634/theoncologist.2010-S4-05.
CrossRef - PubMed - El-Serag HB, Marrero JA, Rudolph L, Reddy KR. Diagnosis and treatment of
hepatocellular carcinoma. Gastroenterology. 2008;134(6):1752-1763. doi:
10.1053/j.gastro.2008.02.090.
CrossRef - PubMed - Clark HP, Carson WF, Kavanagh PV, Ho CP, Shen P, Zagoria RJ. Staging and
current treatment of hepatocellular carcinoma. Radiographics. 2005;25(suppl
1):S3-S23.
CrossRef - PubMed - Llovet JM, Burroughs A, Bruix J. Hepatocellular carcinoma. Lancet.
2003;362(9399):1907-1917.
CrossRef - PubMed - Bruix J, Sherman M; Practice Guidelines Committee, American Association
for the Study of Liver Diseases. Management of hepatocellular carcinoma.
Hepatology. 2005;42(5):1208-1236.
CrossRef - PubMed - Bruix J, Sherman M; American Association for the Study of Liver
Diseases. Management of hepatocellular carcinoma: an update. Hepatology.
2011;53(3):1020-1022.
CrossRef - PubMed - Sala M, Llovet JM, Vilana R, et al. Initial response to percutaneous
ablation predicts survival in patients with hepatocellular carcinoma.
Hepatology. 2004;40(6):1352-1360.
CrossRef - PubMed - McGahan JP, Browning PD, Brock JM, Tesluk H. Hepatic ablation using
radiofrequency electrocautery. Invest Radiol. 1990;25(3):267-270.
CrossRef - PubMed - Simon CJ, Dupuy DE, Mayo-Smith WW. Microwave ablation: principles and
applications. Radiographics. 2005;25(suppl 1):S69-S83.
PubMed - Fan W, Li X, Zhang L, Jiang H, Zhang J. Comparison of microwave ablation
and multipolar radiofrequency ablation in vivo using two internally cooled
probes. AJR Am J Roentgenol. 2012;198(1):W46-W50.
CrossRef - PubMed - Kwon JH. Is percutaneous ethanol injection therapy still effective for
hepatocellular carcinoma in the era of radiofrequency ablation? Gut Liver.
2010;4(suppl 1):S105-S112.
CrossRef - PubMed - Lin SM, Lin CJ, Lin CC, Hsu CW, Chen YC. Randomised controlled trial
comparing percutaneous radiofrequency thermal ablation, percutaneous ethanol
injection, and percutaneous acetic acid injection to treat hepatocellular
carcinoma of 3 cm or less. Gut. 2005;54(8):1151-1156.
CrossRef - PubMed - Cheung W, Kavnoudias H, Roberts S, Szkandera B, Kemp W, Thomson KR.
Irreversible electroporation for unresectable hepatocellular carcinoma:
initial experience and review of safety and outcomes. Technol Cancer Res
Treat. 2013;12(3):233-241.
CrossRef - PubMed - Huo TI, Lin HC, Hsia CY, et al. The model for end-stage liver disease
based cancer staging systems are better prognostic models for hepatocellular
carcinoma: a prospective sequential survey. Am J Gastroenterol.
2007;102(9):1920-1930.
CrossRef - PubMed - Crocetti L, de Baere T, Lencioni R. Quality improvement guidelines for
radiofrequency ablation of liver tumours. Cardiovasc Intervent Radiol.
2010;33(1):11-17.
CrossRef - PubMed - Livraghi T, Meloni F, Di Stasi M, et al. Sustained complete response and
complications rates after radiofrequency ablation of very early
hepatocellular carcinoma in cirrhosis: Is resection still the treatment of
choice? Hepatology. 2008;47(1):82-89.
CrossRef - PubMed - Lencioni RA, Allgaier HP, Cioni D, et al. Small hepatocellular carcinoma
in cirrhosis: randomized comparison of radio-frequency thermal ablation
versus percutaneous ethanol injection. Radiology. 2003;228(1):235-240.
PubMed - El-Serag HB. Hepatocellular carcinoma. N Engl J Med.
2011;365(12):1118-1127.
CrossRef - PubMed - Lencioni R, Crocetti L, De Simone P, Filipponi F. Loco-regional
interventional treatment of hepatocellular carcinoma: techniques, outcomes,
and future prospects. Transpl Int. 2010;23(7):698-703.
CrossRef - PubMed - Ni JY, Liu SS, Xu LF, Sun HL, Chen YT. Meta-analysis of radiofrequency
ablation in combination with transarterial chemoembolization for
hepatocellular carcinoma. World J Gastroenterol. 2013;19(24):3872-3882.
CrossRef - PubMed - Vivarelli M, Guglielmi A, Ruzzenente A, et al. Surgical resection versus
percutaneous radiofrequency ablation in the treatment of hepatocellular
carcinoma on cirrhotic liver. Ann Surg. 2004;240(1):102-107.
CrossRef - PubMed - Ruzzenente A, Guglielmi A, Sandri M, et al. Surgical resection versus
local ablation for HCC on cirrhosis: results from a propensity case-matched
study. J Gastrointest Surg. 2012;16(2):301-311; discussion 311.
CrossRef - PubMed - Lu DS, Yu NC, Raman SS, et al. Radiofrequency ablation of hepatocellular
carcinoma: treatment success as defined by histologic examination of the
explanted liver. Radiology. 2005;234(3):954-960.
PubMed - Brillet PY, Paradis V, Brancatelli G, et al. Percutaneous radiofrequency
ablation for hepatocellular carcinoma before liver transplantation: a
prospective study with histopathologic comparison. AJR Am J Roentgenol.
2006;186(suppl 5):S296-S305.
CrossRef - PubMed - Veltri A, Moretto P, Doriguzzi A, Pagano E, Carrara G, Gandini G.
Radiofrequency thermal ablation (RFA) after transarterial chemoembolization
(TACE) as a combined therapy for unresectable non-early hepatocellular
carcinoma (HCC). Eur Radiol. 2006;16(3):661-669.
CrossRef - PubMed - Kim JW, Shin SS, Kim JK, et al. Radiofrequency ablation combined with
transcatheter arterial chemoembolization for the treatment of single
hepatocellular carcinoma of 2 to 5 cm in diameter: comparison with surgical
resection. Korean J Radiol. 2013;14(4):626-635.
CrossRef - PubMed - Morimoto M, Numata K, Kondou M, Nozaki A, Morita S, Tanaka K. Midterm
outcomes in patients with intermediate-sized hepatocellular carcinoma: a
randomized controlled trial for determining the efficacy of radiofrequency
ablation combined with transcatheter arterial chemoembolization. Cancer.
2010;116(23):5452-5460.
CrossRef - PubMed

Volume : 12
Issue : 1
Pages : 55 - 59
DOI : 10.6002/ect.25Liver.L52
From the Department of Radiology, Baskent University Faculty of Medicine,
Ankara, Turkey
Corresponding author: Prof. Dr. Fatih Boyvat, Baskent University Medical
Faculty, Department of Radiology, Fevzi Cakmak Cad. 10. Sok. No.45,
Bahcelievler, Ankara, Turkey
Phone: +90 312 212 6868 ext:1015
E-mail: boyvatf@yahoo.com

Figure 1. Ultrasound Shows Radiofrequency Prongs in the Periphery of Hepatocellular Carcinoma Nodule

Figure 2. During Radiofrequency Ablation, Nitrogen Gas Formation, Prevents Ultrasonography Visualization

Figure 3 and 4. Computed Tomography Images Demonstrate Exact Placement of Radiofrequency Needle

Figure 5 and 6. Hypervascular Hepatocellular Carcinoma Nodule in the Segment V of Liver, and Selective Embolization With Drug Eluting Bead-Transarterial Chemoembolization

Figure 7 and 8. Ultrasonography Visualization of Hepatocellular Carcinoma Nodule Before and After Selective Chemoembolization

Figure 9. One-month Follow-Up, Computed Tomography Images of the Hepatocellular Carcinoma Nodule That Combined (Drug Eluting BeadTransarterial Chemoembolization + Radiofrequency Ablation) Procedure Was Applied. No Residual or Recurrent Lesion

Figure 10. Computed Tomography Image Shows Complete Ablation of Hepatocellular Carcinoma Nodule
Figure 11. Computed Tomography Image Demonstrates Hypervascular Nodular Enhancement in the Periphery of the Ablated Zone That Shows Residual Hepatocellular Carcinoma Tissue